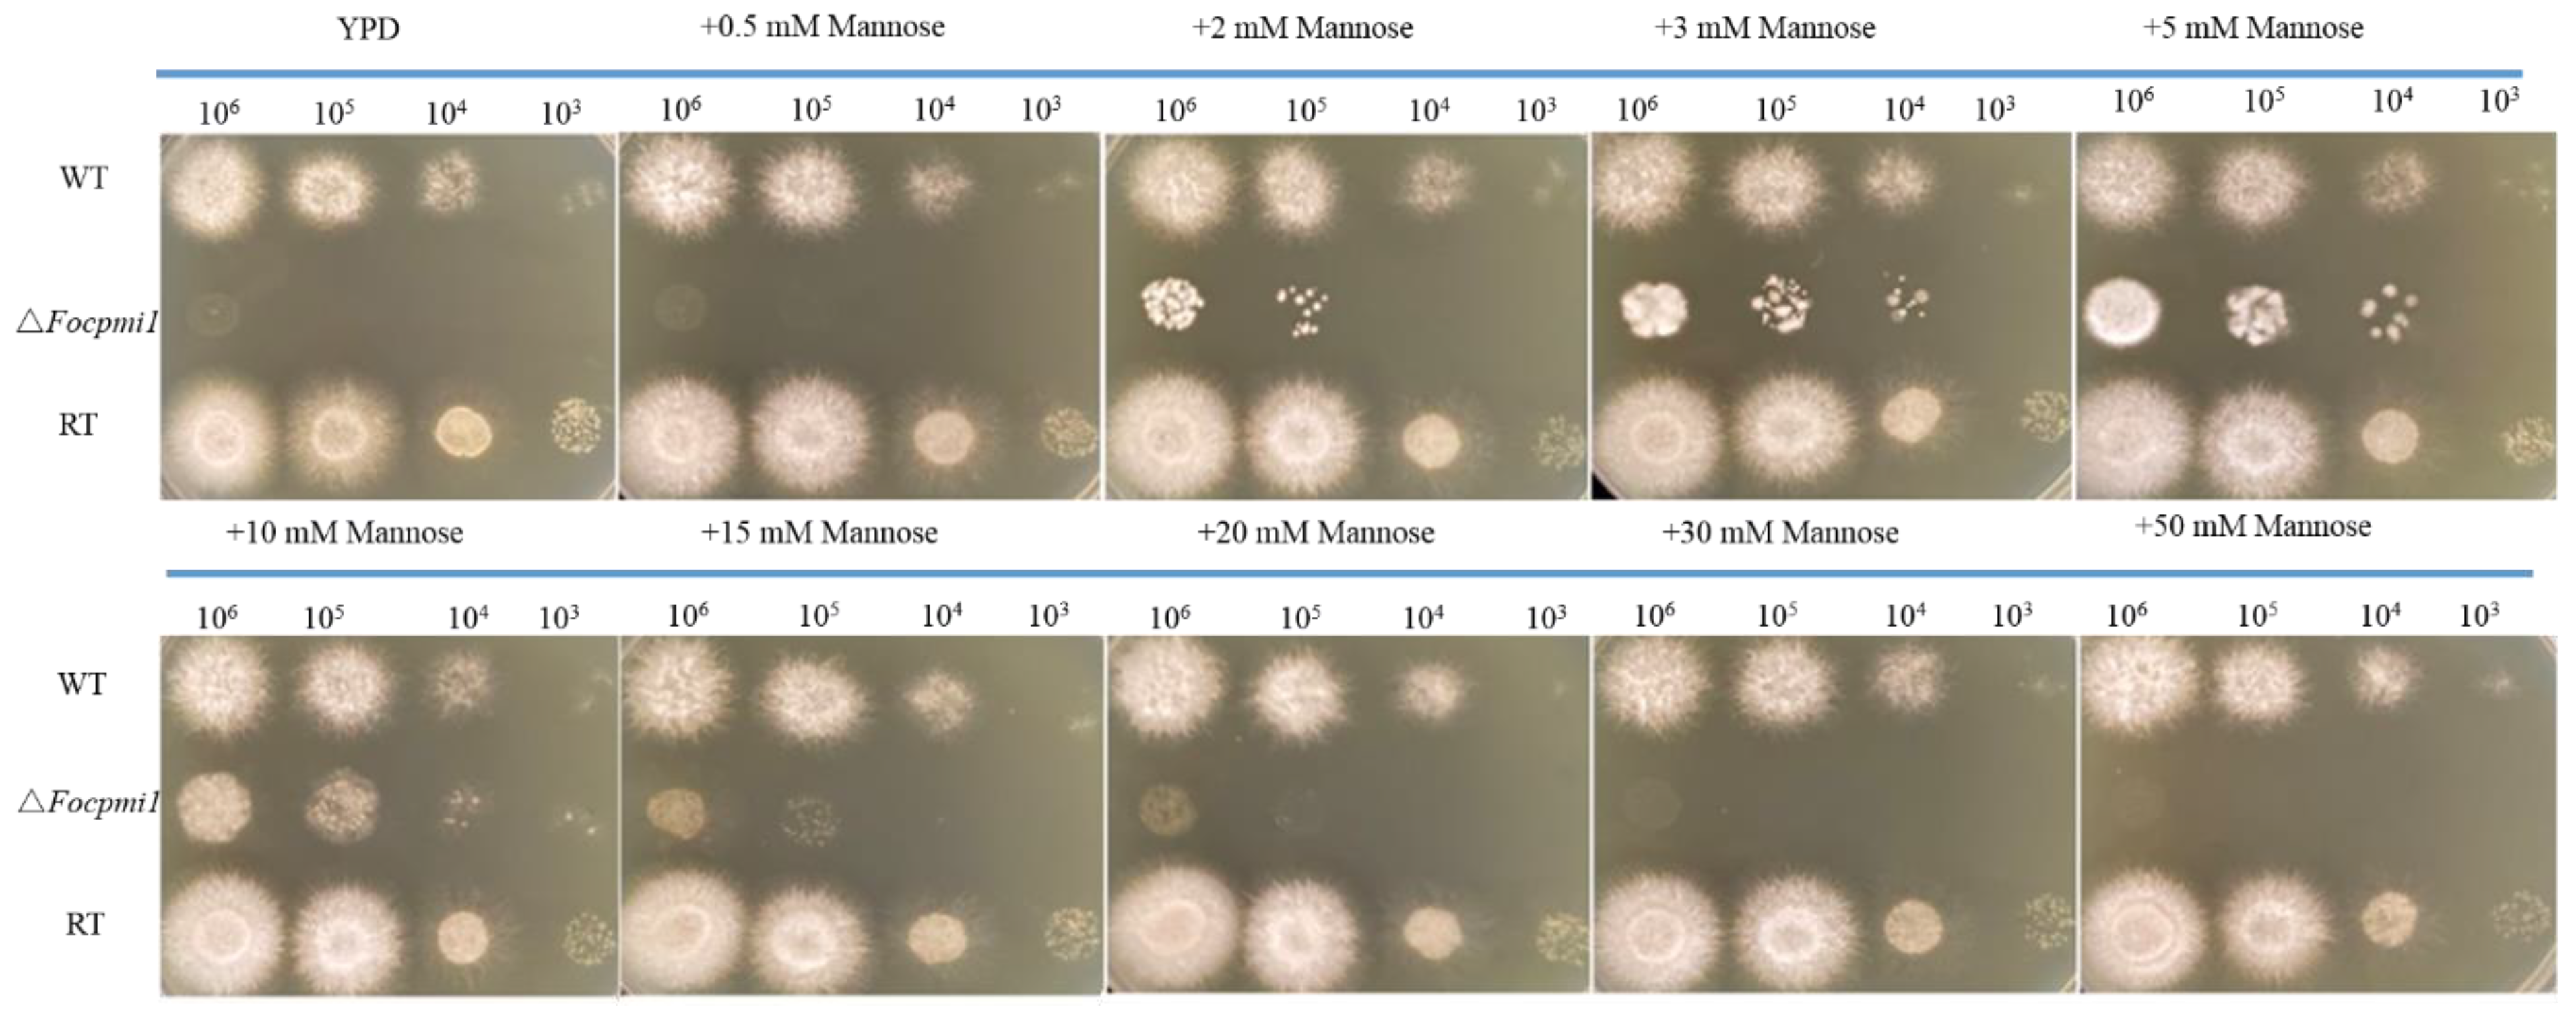
Jof 09 00478 g002
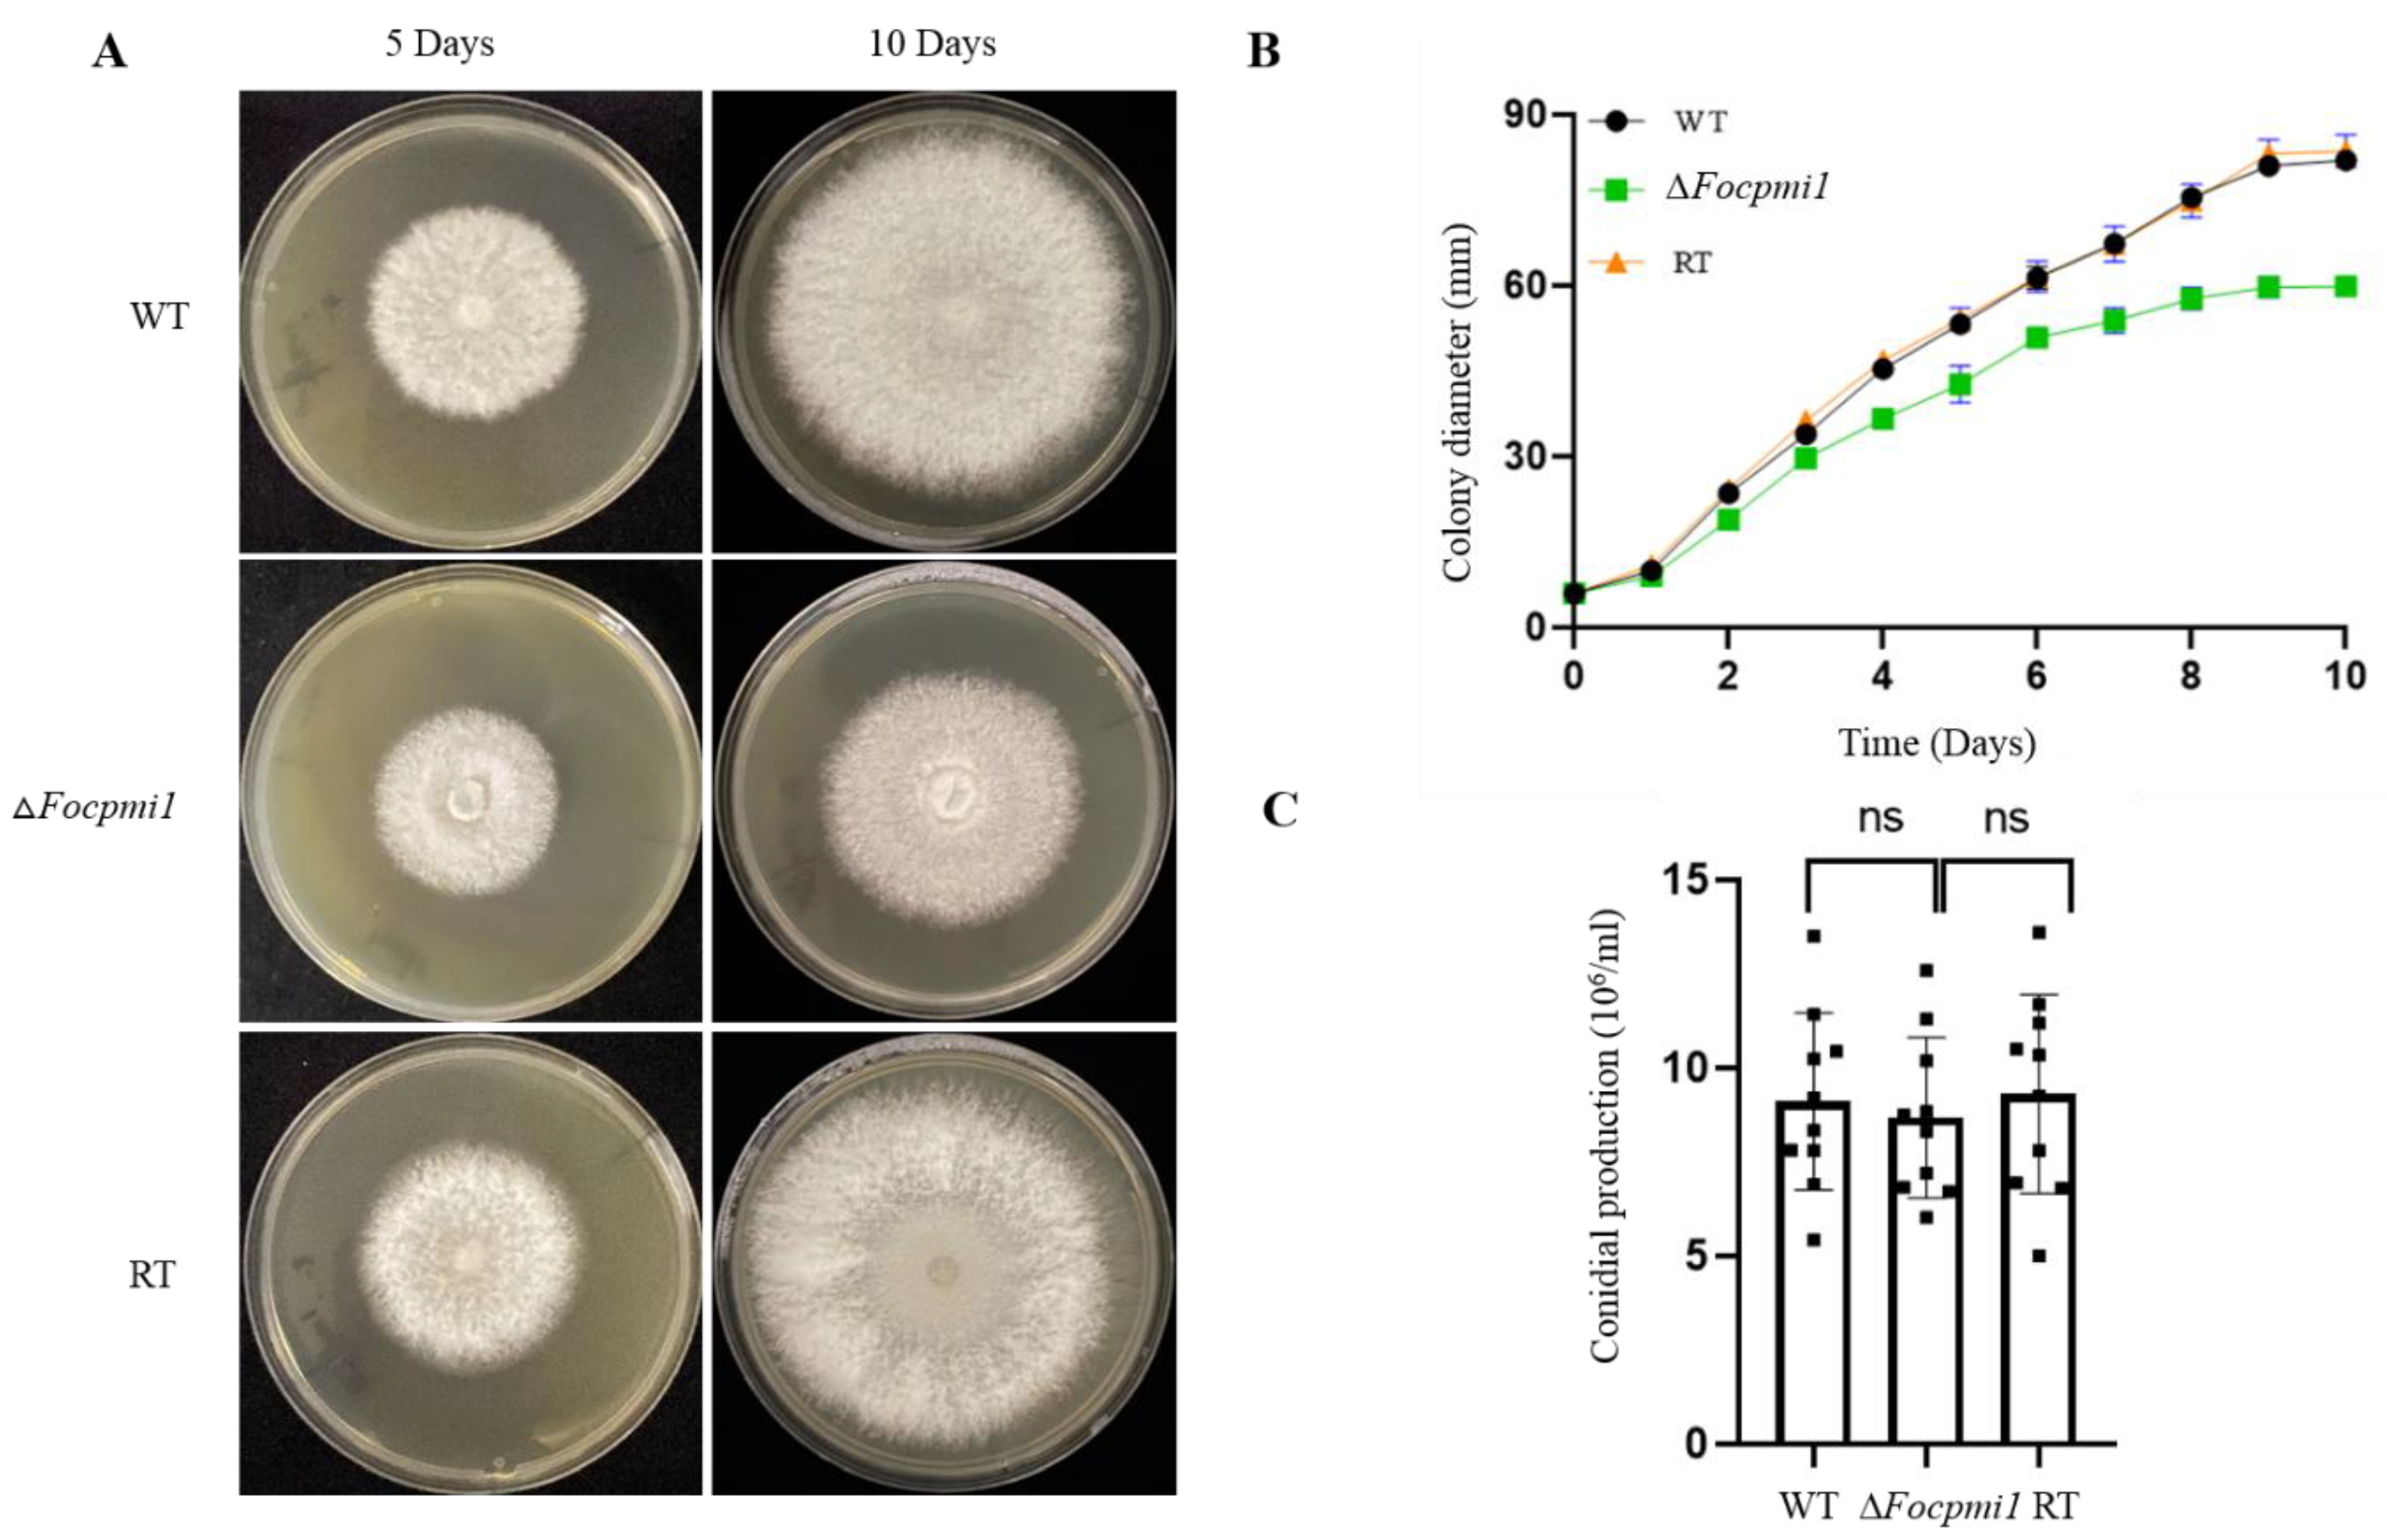
Jof 09 00478 g003

Loss of Phosphomannose Isomerase Impairs Growth, Perturbs Cell Wall Integrity, and Reduces Virulence of Fusarium oxysporum f. sp. cubense on Banana Plants
Abstract
1. Introduction
2. Materials and Methods
2.1. Fungal Strains, Plasmids and Culture Conditions
2.2. Phylogenetic Analysis
2.3. Gene Expression Analysis of Focpmi1 and Focpmi2
2.4. Construction of Deletion Mutant and Revertant Strain
2.5. Confirmation of the Mutant and Revertant Strains
2.6. Effect of Exogenous Mannose on the Growth of the Strains
2.7. Colony Growth Rate and Conidiation Analysis
2.8. Sensitivity to Different Carbon Sources and Stresses
2.9. Cell Wall Components Analysis
2.10. Comparative Transcriptomic Analysis
2.11. Virulence Assay
2.12. Statistical Analysis
3. Results
3.1. Phylogenetic Analysis of Phosphomannose Isomerase in Foc TR4
3.2. Focpmi1 Exhibits High Expression during Conidial, Germination and Mycelium Stages
3.3. Generation of the pmi1 Knockout Mutant and Revertant Strain
3.4. The ∆Focpmi1 Mutant Requires Exogenous Mannose for Growth
3.5. The Growth of the ∆Focpmi1 Mutant Could Not Be Supported by Fructose and Other Carbon Sources
3.6. Focpmi1 Is Involved in Vegetative Growth but Has No Effect on Conidial Production
3.7. Focpmi1 Is Involved in Maintaining Cell Wall Integrity and Stress Tolerance
3.8. Focpmi1 Modulates the Expression of Genes Involved in Carbohydrate, Lipid, and Amino Acid Metabolism
3.9. Focpmi1 Is Required for Foc TR4 Infection and Virulence
4. Discussion
5. Conclusions
Supplementary Materials
Author Contributions
Funding
Institutional Review Board Statement
Informed Consent Statement
Data Availability Statement
Conflicts of Interest
References
- Munkvold, G.P.; Proctor, R.H.; Moretti, A. Mycotoxin production in Fusarium according to contemporary species concepts. Annu. Rev. Phytopathol. 2021, 59, 373–402. [Google Scholar] [CrossRef]
- Dean, R.; Van Kan, J.A.; Pretorius, Z.A.; Hammond-Kosack, K.E.; Di Pietro, A.; Spanu, P.D.; Rudd, J.J.; Dickman, M.; Kahmann, R.; Ellis, J. The Top 10 fungal pathogens in molecular plant pathology. Mol. Plant Pathol. 2012, 13, 414–430. [Google Scholar] [CrossRef] [PubMed]
- Michielse, C.B.; Rep, M. Pathogen profile update: Fusarium oxysporum. Mol. Plant Pathol. 2009, 10, 311. [Google Scholar] [CrossRef] [PubMed]
- Zhou, H.; Xu, Y.; Ebel, F.; Jin, C. Galactofuranose (Gal f)-containing sugar chain contributes to the hyphal growth, conidiation and virulence of F. oxysporum f. sp. cucumerinum. PLoS ONE 2021, 16, e0250064. [Google Scholar] [CrossRef]
- Ashraf, H.; Anjum, T.; Riaz, S.; Batool, T.; Naseem, S.; Li, G. Sustainable synthesis of microwave-assisted IONPs using Spinacia oleracea L. for control of fungal wilt by modulating the defense system in tomato plants. J. Nanobiotechnol. 2022, 20, 8. [Google Scholar] [CrossRef]
- O’Donnell, K.; Sutton, D.A.; Rinaldi, M.G.; Magnon, K.C.; Cox, P.A.; Revankar, S.G.; Sanche, S.; Geiser, D.M.; Juba, J.H.; Van Burik, J.-A.H. Genetic diversity of human pathogenic members of the Fusarium oxysporum complex inferred from multilocus DNA sequence data and amplified fragment length polymorphism analyses: Evidence for the recent dispersion of a geographically widespread clonal lineage and nosocomial origin. J. Clin. Microbiol. 2004, 42, 5109–5120. [Google Scholar] [PubMed]
- Dong, H.; Ye, Y.; Guo, Y.; Li, H. Comparative transcriptome analysis revealed resistance differences of Cavendish bananas to Fusarium oxysporum f. sp. cubense race1 and race4. BMC Genet. 2020, 21, 122. [Google Scholar] [CrossRef]
- Wang, Y.; Zhang, X.; Wang, T.; Zhou, S.; Liang, X.; Xie, C.; Kang, Z.; Chen, D.; Zheng, L. The Small Secreted Protein FoSsp1 Elicits Plant Defenses and Negatively Regulates Pathogenesis in Fusarium oxysporum f. sp. cubense (Foc4). Front. Plant Sci. 2022, 13, 873451. [Google Scholar] [CrossRef]
- Olivares, B.O.; Rey, J.C.; Lobo, D.; Navas-Cortés, J.A.; Gómez, J.A.; Landa, B.B. Fusarium wilt of bananas: A review of agro-environmental factors in the Venezuelan production system affecting its development. Agronomy 2021, 11, 986. [Google Scholar] [CrossRef]
- Huang, H.; Zhang, X.; Zhang, Y.; Yi, G.; Xie, J.; Viljoen, A.; Wang, W.; Mostert, D.; Fu, G.; Peng, C. FocECM33, a GPI-anchored protein, regulates vegetative growth and virulence in Fusarium oxysporum f. sp. cubense tropical race 4. Fungal Biol. 2022, 126, 213–223. [Google Scholar] [CrossRef]
- Segura-Mena, R.; Stoorvogel, J.; García-Bastidas, F.; Salacinas-Niez, M.; Kema, G.; Sandoval, J.A. Evaluating the potential of soil management to reduce the effect of Fusarium oxysporum f. sp. cubense in banana (Musa AAA). Eur. J. Plant Pathol. 2021, 160, 441–455. [Google Scholar] [CrossRef]
- Dong, Z.; Luo, M.; Wang, Z. An Exo-Polygalacturonase Pgc4 Regulates Aerial Hyphal Growth and Virulence in Fusarium oxysporum f. sp. cubense race 4. Int. J. Mol. Sci. 2020, 21, 5886. [Google Scholar] [CrossRef]
- Patel, P.K.; Free, S.J. The genetics and biochemistry of cell wall structure and synthesis in Neurospora crassa, a model filamentous fungus. Front. Microbiol. 2019, 10, 2294. [Google Scholar] [CrossRef] [PubMed]
- Schoffelmeer, E.A.; Klis, F.M.; Sietsma, J.; Cornelissen, B.J. The cell wall of Fusarium oxysporum. Fungal Genet. Biol. 1999, 27, 275–282. [Google Scholar] [CrossRef] [PubMed]
- Plaza, V.; Silva-Moreno, E.; Castillo, L. Breakpoint: Cell wall and glycoproteins and their crucial role in the phytopathogenic fungi infection. Curr. Protein Pept. Sci. 2020, 21, 227–244. [Google Scholar] [CrossRef]
- Garcia-Rubio, R.; de Oliveira, H.C.; Rivera, J.; Trevijano-Contador, N. The fungal cell wall: Candida, Cryptococcus, and Aspergillus species. Front. Microbiol. 2020, 10, 2993. [Google Scholar] [CrossRef]
- Yoshimi, A.; Miyazawa, K.; Kawauchi, M.; Abe, K. Cell Wall Integrity and Its Industrial Applications in Filamentous Fungi. J. Fungi 2022, 8, 435. [Google Scholar] [CrossRef]
- Gow, N.A.; Latge, J.-P.; Munro, C.A. The fungal cell wall: Structure, biosynthesis, and function. Microbiol. Spectr. 2017, 5, 5.3.01. [Google Scholar] [CrossRef]
- Lockhart, D.E.; Stanley, M.; Raimi, O.G.; Robinson, D.A.; Boldovjakova, D.; Squair, D.R.; Ferenbach, A.T.; Fang, W.; van Aalten, D.M. Targeting a critical step in fungal hexosamine biosynthesis. J. Biol. Chem. 2020, 295, 8678–8691. [Google Scholar] [CrossRef]
- Fang, W.; Du, T.; Raimi, O.G.; Hurtado-Guerrero, R.; Mariño, K.; Ibrahim, A.F.; Albarbarawi, O.; Ferguson, M.A.; Jin, C.; Van Aalten, D.M. Genetic and structural validation of Aspergillus fumigatus N-acetylphosphoglucosamine mutase as an antifungal target. Biosci. Rep. 2013, 33, e00063. [Google Scholar] [CrossRef]
- Fang, W.; Du, T.; Raimi, O.G.; Hurtado-Guerrero, R.; Urbaniak, M.D.; Ibrahim, A.F.; Ferguson, M.A.; Jin, C.; van Aalten, D.M. Genetic and structural validation of A spergillus fumigatus UDP-N-acetylglucosamine pyrophosphorylase as an antifungal target. Mol. Microbiol. 2013, 89, 479–493. [Google Scholar] [CrossRef] [PubMed]
- Zhang, Y.; Fang, W.; Raimi, O.G.; Lockhart, D.E.; Ferenbach, A.T.; Lu, L.; van Aalten, D.M. Genetic and structural validation of phosphomannomutase as a cell wall target in Aspergillus fumigatus. Mol. Microbiol. 2021, 116, 245–259. [Google Scholar] [CrossRef] [PubMed]
- Yan, K.; Stanley, M.; Kowalski, B.; Raimi, O.G.; Ferenbach, A.T.; Wei, P.; Fang, W.; van Aalten, D.M. Genetic validation of Aspergillus fumigatus phosphoglucomutase as a viable therapeutic target in invasive aspergillosis. J. Biol. Chem. 2022, 298, 102003. [Google Scholar] [CrossRef] [PubMed]
- Zhou, Y.; Yan, K.; Qin, Q.; Raimi, O.G.; Du, C.; Wang, B.; Ahamefule, C.S.; Kowalski, B.; Jin, C.; van Aalten, D.M. Phosphoglucose isomerase is important for Aspergillus fumigatus cell wall biogenesis. mBio 2022, 13, e01426-22. [Google Scholar] [CrossRef] [PubMed]
- Barcelos, M.P.; Federico, L.B.; Taft, C.A.; de Paula da Silva, C.H. Prediction of the Three-Dimensional Structure of Phosphate-6-mannose PMI Present in the Cell Membrane of Xanthomonas citri subsp. citri of Interest for the Citrus Canker Control. Emerging Research in Science and Engineering Based on Advanced Experimental and Computational Strategies; Springer: Berlin/Heidelberg, Germany, 2020; pp. 259–276. [Google Scholar]
- Usman, S.; Du, C.; Qin, Q.; Odiba, A.S.; He, R.; Wang, B.; Jin, C.; Fang, W. Phosphomannose Isomerase Is Involved in Development, Stress Responses, and Pathogenicity of Aspergillus flavus. Microbiol. Spectr. 2022, 10, e02027-22. [Google Scholar] [CrossRef]
- Fang, W.; Yu, X.; Wang, B.; Zhou, H.; Ouyang, H.; Ming, J.; Jin, C. Characterization of the Aspergillus fumigatus phosphomannose isomerase Pmi1 and its impact on cell wall synthesis and morphogenesis. Microbiology 2009, 155, 3281–3293. [Google Scholar] [CrossRef]
- Garami, A.; Ilg, T. The role of phosphomannose isomerase in Leishmania mexicana glycoconjugate synthesis and virulence. J. Biol. Chem. 2001, 276, 6566–6575. [Google Scholar] [CrossRef]
- Cao, Y.; Li, M.; Xia, Y. Mapmi gene contributes to stress tolerance and virulence of the entomopathogenic fungus, Metarhizium acridum. J. Invertebr. Pathol. 2011, 108, 7–12. [Google Scholar] [CrossRef]
- Wills, E.A.; Roberts, I.S.; Del Poeta, M.; Rivera, J.; Casadevall, A.; Cox, G.M.; Perfect, J.R. Identification and characterization of the Cryptococcus neoformans phosphomannose isomerase-encoding gene, MAN1, and its impact on pathogenicity. Mol. Microbiol. 2001, 40, 610–620. [Google Scholar] [CrossRef] [PubMed]
- Hall, B.G. Building phylogenetic trees from molecular data with MEGA. Mol. Biol. Evol. 2013, 30, 1229–1235. [Google Scholar] [CrossRef]
- Livak, K.J.; Schmittgen, T.D. Analysis of relative gene expression data using real-time quantitative PCR and the 2−ΔΔCT method. Methods 2001, 25, 402–408. [Google Scholar] [CrossRef] [PubMed]
- Sarrocco, S.; Falaschi, N.; Vergara, M.; Nicoletti, F.; Vannacci, G. Use of Fusarium oxysporum f. sp. dianthi transformed with marker genes to follow colonization of carnation roots. J. Plant Pathol. 2007, 89, 47–54. [Google Scholar]
- Francois, J.M. A simple method for quantitative determination of polysaccharides in fungal cell walls. Nat. Protoc. 2006, 1, 2995–3000. [Google Scholar] [CrossRef]
- García-Bastidas, F.A.; Van der Veen, A.J.; Nakasato-Tagami, G.; Meijer, H.J.; Arango-Isaza, R.E.; Kema, G.H. An improved phenotyping protocol for Panama disease in banana. Front. Plant Sci. 2019, 10, 1006. [Google Scholar] [CrossRef] [PubMed]
- Arvanitoyannis, I.S.; Mavromatis, A.G.; Grammatikaki-Avgeli, G.; Sakellariou, M. Banana: Cultivars, biotechnological approaches and genetic transformation. Int. J. Food Sci. Technol. 2008, 43, 1871–1879. [Google Scholar] [CrossRef]
- Nelson, S.C.; Ploetz, R.C.; Kepler, A.K. Musa species (banana and plantain). Species Profiles Pac. Isl. Agrofor. 2006, 15, 251–259. [Google Scholar]
- Li, C.; Yang, J.; Li, W.; Sun, J.; Peng, M. Direct root penetration and rhizome vascular colonization by Fusarium oxysporum f. sp. cubense are the key steps in the successful infection of Brazil Cavendish. Plant Dis. 2017, 101, 2073–2078. [Google Scholar] [CrossRef] [PubMed]
- Ghag, S.B.; Shekhawat, U.K.; Ganapathi, T.R. Fusarium wilt of banana: Biology, epidemiology and management. Int. J. Pest Manag. 2015, 61, 250–263. [Google Scholar] [CrossRef]
- Gordon, T.R. Fusarium oxysporum and the Fusarium wilt syndrome. Annu. Rev. Phytopathol. 2017, 55, 23–39. [Google Scholar] [CrossRef]
- Li, C.; Chen, S.; Zuo, C.; Sun, Q.; Ye, Q.; Yi, G.; Huang, B. The use of GFP-transformed isolates to study infection of banana with Fusarium oxysporum f. sp. cubense race 4. Eur. J. Plant Pathol. 2011, 131, 327–340. [Google Scholar] [CrossRef]
- Li, X.; Li, K.; Zhou, D.; Zhang, M.; Qi, D.; Jing, T.; Zang, X.; Qi, C.; Wang, W.; Xie, J. Biological control of banana wilt disease caused by Fusarium oxyspoum f. sp. Cubense using Streptomyces sp. H4. Biol. Control 2021, 155, 104524. [Google Scholar] [CrossRef]
- Cortes, J.C.G.; Curto, M.-Á.; Carvalho, V.S.; Perez, P.; Ribas, J.C. The fungal cell wall as a target for the development of new antifungal therapies. Biotechnol. Adv. 2019, 37, 107352. [Google Scholar] [CrossRef] [PubMed]
- Colosimo, R.; Warren, F.J.; Edwards, C.H.; Ryden, P.; Dyer, P.S.; Finnigan, T.J.; Wilde, P.J. Comparison of the behavior of fungal and plant cell wall during gastrointestinal digestion and resulting health effects: A review. Trends Food Sci. Technol. 2021, 110, 132–141. [Google Scholar] [CrossRef]
- Liu, W.; Yuan, L.; Wang, S. Recent progress in the discovery of antifungal agents targeting the cell wall. J. Med. Chem. 2020, 63, 12429–12459. [Google Scholar] [CrossRef]
- de la Fuente, M.; Penas, P.F.; Sols, A. Mechanism of mannose toxicity. Biochem. Biophys. Res. Commun. 1986, 140, 51–55. [Google Scholar] [CrossRef]
- Adnan, M.; Zheng, W.; Islam, W.; Arif, M.; Abubakar, Y.S.; Wang, Z.; Lu, G. Carbon catabolite repression in filamentous fungi. Int. J. Mol. Sci. 2017, 19, 48. [Google Scholar] [CrossRef]
- Borgia, P.T.; Dodge, C.L. Characterization of Aspergillus nidulans mutants deficient in cell wall chitin or glucan. J. Bacteriol. 1992, 174, 377–383. [Google Scholar] [CrossRef]

Disclaimer/Publisher’s Note: The statements, opinions and data contained in all publications are solely those of the individual author(s) and contributor(s) and not of MDPI and/or the editor(s). MDPI and/or the editor(s) disclaim responsibility for any injury to people or property resulting from any ideas, methods, instructions or products referred to in the content. |
© 2023 by the authors. Licensee MDPI, Basel, Switzerland. This article is an open access article distributed under the terms and conditions of the Creative Commons Attribution (CC BY) license (https://creativecommons.org/licenses/by/4.0/).
Share and Cite
Usman, S.; Ge, X.; Xu, Y.; Qin, Q.; Xie, J.; Wang, B.; Jin, C.; Fang, W. Loss of Phosphomannose Isomerase Impairs Growth, Perturbs Cell Wall Integrity, and Reduces Virulence of Fusarium oxysporum f. sp. cubense on Banana Plants. J. Fungi 2023, 9, 478. https://doi.org/10.3390/jof9040478
Usman S, Ge X, Xu Y, Qin Q, Xie J, Wang B, Jin C, Fang W. Loss of Phosphomannose Isomerase Impairs Growth, Perturbs Cell Wall Integrity, and Reduces Virulence of Fusarium oxysporum f. sp. cubense on Banana Plants. Journal of Fungi. 2023; 9(4):478. https://doi.org/10.3390/jof9040478
Chicago/Turabian StyleUsman, Sayed, Xinwei Ge, Yueqiang Xu, Qijian Qin, Jin Xie, Bin Wang, Cheng Jin, and Wenxia Fang. 2023. "Loss of Phosphomannose Isomerase Impairs Growth, Perturbs Cell Wall Integrity, and Reduces Virulence of Fusarium oxysporum f. sp. cubense on Banana Plants" Journal of Fungi 9, no. 4: 478. https://doi.org/10.3390/jof9040478
APA StyleUsman, S., Ge, X., Xu, Y., Qin, Q., Xie, J., Wang, B., Jin, C., & Fang, W. (2023). Loss of Phosphomannose Isomerase Impairs Growth, Perturbs Cell Wall Integrity, and Reduces Virulence of Fusarium oxysporum f. sp. cubense on Banana Plants. Journal of Fungi, 9(4), 478. https://doi.org/10.3390/jof9040478

